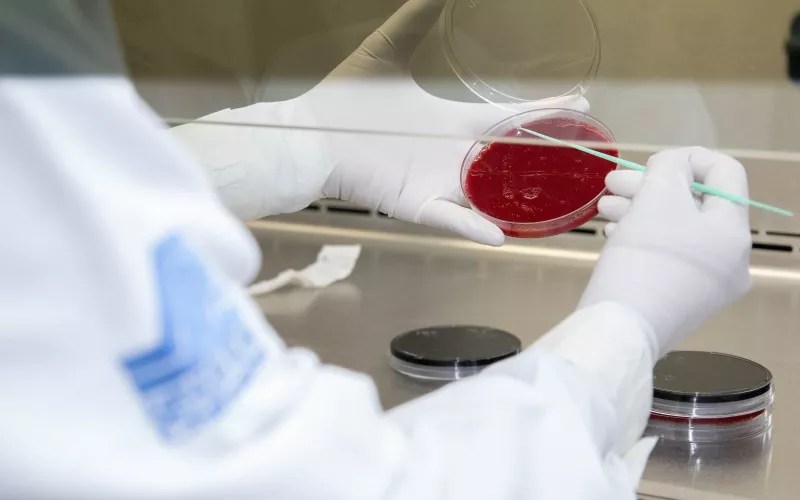

El Instituto de Diagnóstico y Referencia Epidemiológicos (InDRE) ha confirmado que uno de los casos sospechosos de viruela símica (Mpox) en Ciudad Juárez ha resultado negativo. El paciente, que estaba bajo vigilancia, presenta en realidad una infección por varicela y sigue recibiendo tratamiento médico y aislamiento.
Actualmente, una segunda persona en Ciudad Juárez también está aislada mientras se esperan los resultados de sus estudios, que se conocerán en aproximadamente 10 días.
El subdirector de Epidemiología, Gumaro Barrios Gallegos, explicó que la viruela símica es una enfermedad viral que se transmite principalmente por contacto cercano con personas infectadas. Sus síntomas incluyen erupciones en la piel, fiebre, dolor de cabeza y dolor muscular.
El diagnóstico de Mpox se realiza mediante muestras de lesiones dérmicas enviadas al InDRE. Las personas con mayor riesgo de complicaciones incluyen a quienes viven con VIH sin tratamiento, aquellos con enfermedades autoinmunes, embarazadas y niños.
Barrios Gallegos destacó que no hay un tratamiento específico para Mpox, por lo que es importante evitar la propagación del virus. Recomendó a la población mantenerse informada sobre los síntomas y acudir a un centro de salud ante cualquier sospecha, especialmente si han viajado al extranjero o han estado en contacto con casos confirmados. Además, subrayó la importancia de medidas de prevención como el lavado de manos y la higiene corporal.
